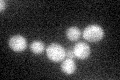
YGR181W

View description
Mitochondrial intermembrane space protein, forms a complex with Tim8p that delivers a subset of hydrophobic proteins to the TIM22 complex for insertion into the inner membrane
Localization:
Intensity:
Fold change:
Significance:
-
C’ GFP library in SD
cytosol21.98 -
N' NOP1pr-GFP in SD

cytosol106.744 -
N' TEF2pr-mCherry in SD

cytosol24.3458 -
N' NATIVEpr-GFP in SD

cytosol39.8506 -
N' TEF2pr-VC and Cyto-VN in SD

#N/A0 -
C’ GFP library in SD+DTT

cytosol22.781.03No -
C’ GFP library in SD+H2O2

cytosol25.751.17No -
C’ GFP library in Starvation Media

cytosol23.841.08No -
C’ GFP library on the background of Pup2-DaMP

cytosol -
C’ GFP library on the background of CCT mutant

cytosol18.49610.841166No
